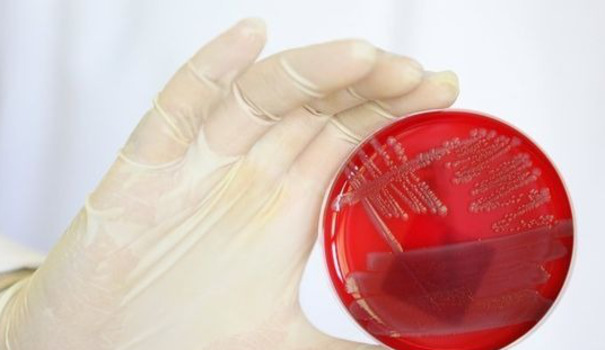

Nous n’en sommes plus au commencement du racisme ordinaire mais nous ne sommes pas loin d’une infection inquiétante.
Ce matin sur Bel RTL, Frédéric Moray a répondu à une des questions les plus souvent posées par les auditeurs dans sa séquence 90 secondes pour comprendre: pourquoi c’est l’Europe qui doit accueillir les réfugiés syriens et pas les pays musulmans voisins ? Une idée fausse. Voici la politique d’accueil des réfugiés dans les pays du Moyen-Orient expliquée.


Build a beautiful stone sink from a that large rock that's been sitting in your yard.